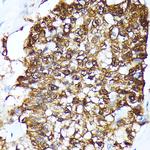
FKBP4 Antibody in Immunohistochemistry (Paraffin) (IHC (P))

Search
Invitrogen
FKBP4 Polyclonal Antibody
{{$productOrderCtrl.translations['antibody.pdp.commerceCard.promotion.promotions']}}
{{$productOrderCtrl.translations['antibody.pdp.commerceCard.promotion.viewpromo']}}
{{$productOrderCtrl.translations['antibody.pdp.commerceCard.promotion.promocode']}}: {{promo.promoCode}} {{promo.promoTitle}} {{promo.promoDescription}}. {{$productOrderCtrl.translations['antibody.pdp.commerceCard.promotion.learnmore']}}

Please note: We are reviewing Western blot images included in the antibody testing data in our catalog, including those provided by third parties. Unless expressly labeled or annotated as “raw-unedited”, Western blot images included in the antibody testing data in our catalog may have been edited, optimized or otherwise adjusted for presentation.
产品信息
PA5-120934
种属反应
宿主/亚型
分类
类型
抗原
偶联物
形式
浓度
规格
纯化类型
保存液
内含物
保存条件
运输条件
RRID
产品详细信息
Positive test controls include: HeLa, Jurkat, Mouse testis, Rat testis. The target is usually found in the following locations: Cytoplasm, Mitochondrion, Nucleus, cytoskeleton, cytosol.
靶标信息
FKBP4, encoding FK506-binding protein 4, is part of the immunophilin family and plays roles in cellular processes like protein folding and trafficking. The FKBP4 gene is located on chromosome 12, where it encodes a protein involved in modulating the androgen receptor signaling pathway and has been implicated in various cancers, including non-small-cell lung cancer (NSCLC) and hepatocellular carcinoma (HCC). Structural variants of FKBP4 found through exome sequencing have shown potential deleterious effects on protein function. This gene is associated with cell proliferation, apoptosis, migration, and invasion in cancer cells. FKBP4 also influences metabolic processes, such as glycolysis, thereby contributing to cancer cell survival and growth. Importantly, FKBP4 has a role in disorders of sexual development due to its regulatory interaction with hormone signaling pathways.
仅用于科研。不用于诊断过程。未经明确授权不得转售。
篇参考文献 (0)
生物信息学
蛋白别名: 51 kDa FK506-binding protein; 52 kDa FK506-binding protein; 52 kDa FKBP; 59 kDa immunophilin; FK506 binding protein 52; FK506-binding protein 4; FKBP-4; FKBP51; FKBP52 protein; FKBP59; HBI; HSP-binding immunophilin; Immunophilin FKBP52; p59; Peptidyl-prolyl cis-trans isomerase FKBP4; PPIase FKBP4; Rotamase
基因别名: 59kDa; AL022792; AW208983; FKBP-4; FKBP-52; FKBP4; FKBP52; FKPB52; p59
UniProt ID: (Mouse) P30416, (Rat) Q9QVC8
Entrez Gene ID: (Mouse) 14228, (Rat) 260321



